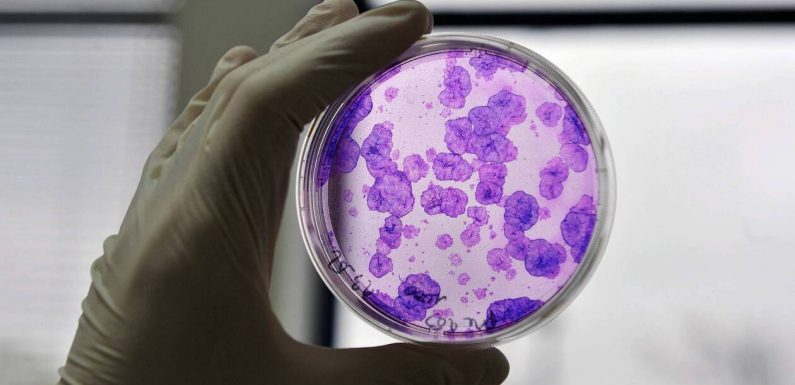
Une nouvelle molécule ouvre la voie à une greffe prometteuse pour les patients atteints de cancer du sang

L’objectif de la recherche était d’abord de vérifier si une telle greffe était sécurisée pour le patient ou la patiente. Mais les résultats sont tels, que les chercheurs de l’Université de Montréal (UdeM) ( Canada ), à l’origine de ces tests, ne peuvent dissimuler leur enthousiasme, comme le rapporte […]
Cliquez ici pour lire la suite Une nouvelle molécule ouvre la voie à une greffe prometteuse pour les patients atteints de cancer du sang









